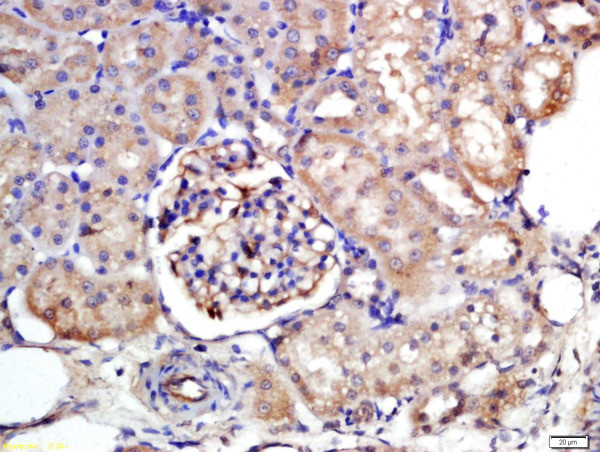
NTCP/SLC10A1 Antibody in Immunohistochemistry (Paraffin) (IHC (P))

Search
Bioss
NTCP/SLC10A1 Polyclonal Antibody
{{$productOrderCtrl.translations['antibody.pdp.commerceCard.promotion.promotions']}}
{{$productOrderCtrl.translations['antibody.pdp.commerceCard.promotion.viewpromo']}}
{{$productOrderCtrl.translations['antibody.pdp.commerceCard.promotion.promocode']}}: {{promo.promoCode}} {{promo.promoTitle}} {{promo.promoDescription}}. {{$productOrderCtrl.translations['antibody.pdp.commerceCard.promotion.learnmore']}}
产品信息
BS-1958R
种属反应
宿主/亚型
分类
类型
抗原
偶联物
形式
浓度
规格
纯化类型
保存液
内含物
保存条件
运输条件
靶标信息
Sodium/bile acid cotransporters are integral membrane glycoproteins that participate in the enterohepatic circulation of bile acids. Two homologous transporters are involved in the reabsorption of bile acids, one absorbing from the intestinal lumen, the bile duct, and the kidney with an apical localization (SLC10A2), and the other being found in the basolateral membranes of hepatocytes (SLC10A1).
仅用于科研。不用于诊断过程。未经明确授权不得转售。
篇参考文献 (0)
生物信息学
蛋白别名: bile acid cotransporting polypeptide; Cell growth-inhibiting gene 29 protein; GIG29; growth-inhibiting protein 29; Hepatic sodium/bile acid cotransporter; Na(+)/bile acid cotransporter; Na(+)/taurocholate transport protein; NA-dependent cholate transporting protein; Na/taurocholate cotransporting polypeptide; NTCP; SLC10A1; sodium bile acid cotransporting polypeptide; sodium-dependent bile acid cotransporter; sodium-dependent taurocholate cotransporting polypeptide; sodium-taurocholate cotransporting polypeptide; sodium/bile acid cotransporter; sodium/tauro; sodium/taurocholate cotransporter; Sodium/taurocholate cotransporting polypeptide; solute carrier family 10 (sodium/bile acid cotransporter family), member 1; solute carrier family 10 (sodium/bile acid cotransporter), member 1; Solute carrier family 10 member 1; solute carrier family 10, member 1; unnamed protein product
基因别名: FHCA2; GIG29; NTCP; Ntcp1; SBACT; SLC10A1
UniProt ID: (Human) Q14973, (Mouse) O08705, (Rat) P26435
Entrez Gene ID: (Human) 6554, (Mouse) 20493, (Rat) 24777